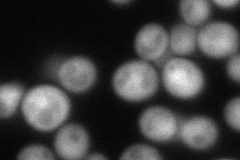
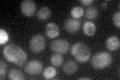

View description
Protein involved in mating response, invasive/filamentous growth, and osmotolerance, acts as an adaptor that links G protein-associated Cdc42p-Ste20p complex to the effector Ste11p to modulate signal transduction
Localization:
Intensity:
Fold change:
Significance:
-
C’ GFP library in SD

cytosol23.49 -
N' NOP1pr-GFP in SD

cytosol61.5386 -
N' TEF2pr-mCherry in SD
cytosol92.8677 -
N' NATIVEpr-GFP in SD

cytosol29.6497 -
N' TEF2pr-VC and Cyto-VN in SD

cytosol36.0967 -
C’ GFP library in SD+DTT

cytosol28.81.22No -
C’ GFP library in SD+H2O2

cytosol27.831.18No -
C’ GFP library in Starvation Media
cytosol36.081.53No -
C’ GFP library on the background of Pup2-DaMP

cytosol -
C’ GFP library on the background of CCT mutant

cytosol22.12930.941953No
